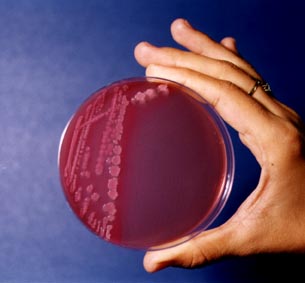

Autore |
Discussione |
|
fpotpot
Utente
 
Città: middleofnowhere
1056 Messaggi |
Inserito il - 31 gennaio 2006 : 10:02:12
|
Salut! qualcuno mi può indicare dei link per saper qualcosina di dettagliato su E.Coli?se siete in grado di scrivere qualcosina di dettagliato e sintetico voi stessi sarebbe ugualmente apprezzato..gracie!!
|
|
|
data
Nuovo Arrivato

Prov.: Torino
Città: Torino
89 Messaggi |
|
fpotpot
Utente
 
Città: middleofnowhere
1056 Messaggi |
Inserito il - 31 gennaio 2006 : 12:55:50
|
niiiiice!!!grazie!!!   |
 |
|
microbo
Nuovo Arrivato

117 Messaggi |
Inserito il - 07 marzo 2007 : 19:40:11
|
http://ecoli.bham.ac.uk/
Immagine:
17,66 KB
Lattosio fermentante, (vedi colonie rosa su MacConkey), ospite normale dell'organismo umano a livello intestinale. Principali quadri patologici: infezioni vie urinarie (80% casi), infezioni intestinali dastipiti EPEC enteropatogeni, EIEC enteroinvasivi, EHEC, enteroemorragici (0157:H7)Gli stipiti EPEC sono provvisti di adesività localizzata con distruzione dei microvilli, gli ETEC hanno una tossina termolabile LT simile a quella colerica e ST termostabile, gli EIEC devono la loro azione patogena ad un fattore di invasività INV e gli EHEC alla verotossina 1 simile a quella di Shigella dysenteriae e verotossina 2 associata alla precedente. Se E.coli è associato all'antigene K1 causa meningite neonatale. Questo antigene è simile all'antigene B di S.agalactiae, tutti agenti etiologici di memningite neonatale. Se hai bisogno ancora, scrivimi!!  |
 |
|
dallolio_gm
Moderatore
  

Prov.: Bo!
Città: Barcelona/Bologna
2445 Messaggi |
Inserito il - 07 marzo 2007 : 19:46:41
|
Mi era rimasto impresso questo elaborato, la 'vita di laboratorio vista dagli occhi di E.Coli' ;) : http://www.molecularlab.it/elaborati/elaborato.asp?n=4 |
Il mio blog di bioinformatics (inglese): BioinfoBlog Sono un po' lento a rispondere, posso tardare anche qualche giorno... ma abbiate fede! :-) |
 |
|
fpotpot
Utente
 
Città: middleofnowhere
1056 Messaggi |
Inserito il - 08 marzo 2007 : 00:15:04
|
gracias hombre!!! |
 |
|
biotech
Utente Junior

Prov.: Padova
Città: Padova
170 Messaggi |
|
|
Discussione |
|